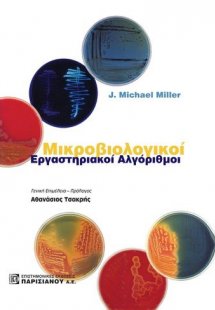
Μικροβιολογικοί εργαστηριακοί αλγόριθμοι

Τρόποι νοσηλευτικής και φαρμακευτικής προσέγγισης ογκολογικών ασθενών
Περιγραφή:
Δίκαια οι ασθενείς με νεοπλασματικά νοσήματα θεωρούνται σήμερα ως χρόνιοι πάσχοντες, λόγω της μακράς επιβίωσης που επιτυγχάνεται σε κακοήθειες που στο παρελθόν είχαν δυσμενή πρόγνωση. Εξάλλου, ο αριθμός των ασθενών που υποβάλλονται σήμερα σε αντινεοπλασματική χημειοθεραπεία, είναι σημαντικά αυξημένος σε σύγκριση με τις προηγούμενες δεκαετίες, κυρίως λόγω της εφαρμογής νεότερων θεραπευτικών σχημάτων με δραστικότητα σε νοσήματα που στο παρελθόν θεωρούνταν ανίατα.
Συνέπεια των ανωτέρω είναι ότι οι γνώσεις είναι απαραίτητες στα άτομα που χειρίζονται τους συγκεκριμένους ασθενείς. Εκτός, όμως, του θεωρητικού μέρος, είναι απαραίτητη και η πρακτική εφαρμογή των γνώσεων που σχετίζονται με τη χημειοθεραπεία και σε αυτό συμβάλλει σημαντικά το βοήθημα που επιμελήθηκε η νοσηλεύτρια Γεωργιάδη Ελπίδα με τίτλο “Τρόποι νοσηλευτικής και φαρμακευτικής προσέγγισης ογκολογικών ασθενών”.
Το συγκεκριμένο βοήθημα είναι πολύπλευρα χρήσιμο στην καθημερινή αντιμετώπιση των ασθενών με νεοπλασίες. Πιστεύω, ότι θα βρει μιμητές για τη συνεχή πληροφόρηση των νοσηλευτών που έχουν συνδέσει τη ζωή τους με το θεάρεστο έργο της παροχής υπηρεσιών σε αυτούς τους ατυχείς συνανθρώπους μας